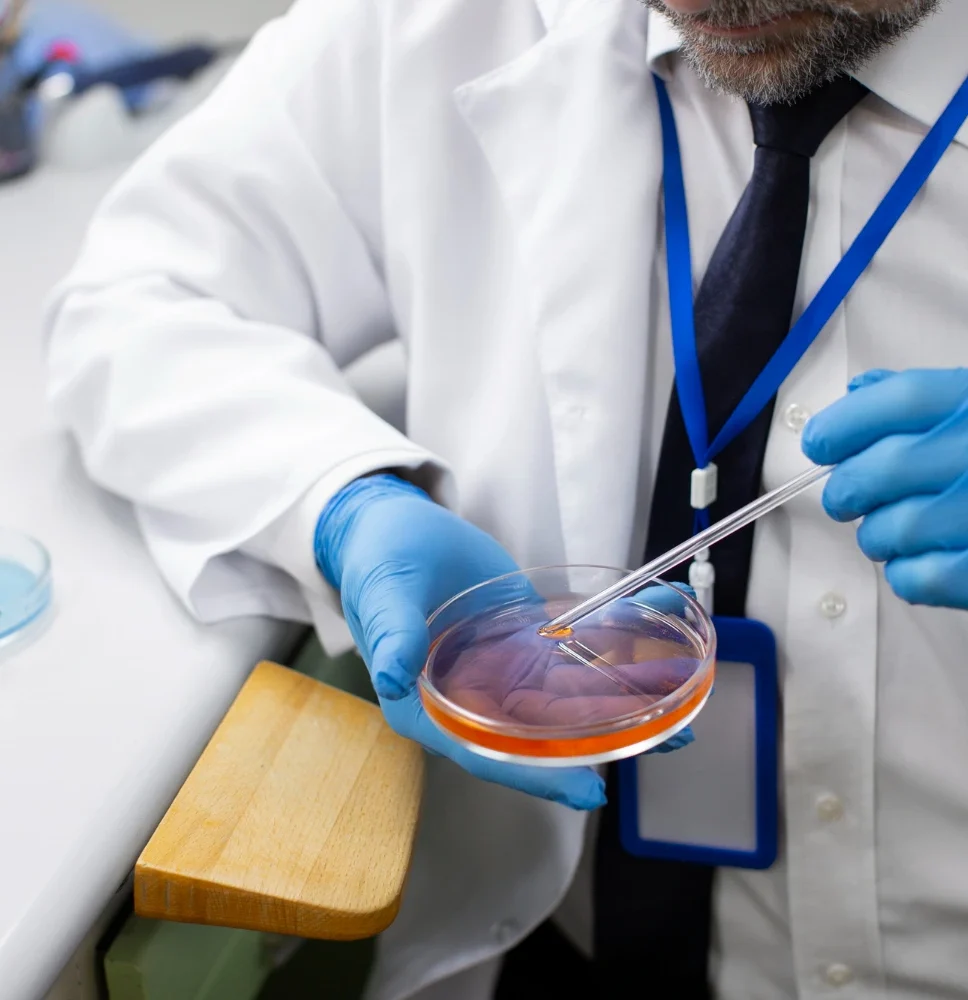

Es el tratamiento de fertilidad más avanzado y efectivo para ayudar a mujeres y parejas a concebir cuando existen dificultades naturales. Consiste en extraer los óvulos, fecundarlos con espermatozoides en un laboratorio especializado y transferir los embriones más viables al útero para lograr el embarazo.
En UBL, utilizamos tecnología de laboratorio de última generación y protocolos personalizados para aumentar tus probabilidades de éxito en cada ciclo.

Cada paciente es diferente, por eso diseñamos un protocolo personalizado según tus necesidades reproductivas.
En nuestra clínica especializada en fertilidad encontrarás soluciones integrales que abarcan desde procedimientos de alta complejidad hasta opciones de preservación de fertilidad y apoyo reproductivo.

El tratamiento más avanzado para lograr un embarazo. Consiste en fecundar los óvulos con espermatozoides en laboratorio y transferir los embriones más viables al útero, aumentando significativamente las probabilidades de éxito.

Opciones menos invasivas para casos específicos. Incluyen estimulación ovárica y control de ovulación bajo supervisión médica, buscando resultados efectivos sin procedimientos quirúrgicos.

Una técnica de alta precisión donde un espermatozoide seleccionado se introduce directamente en el óvulo. Ideal para casos con baja cantidad o movilidad espermática, fallos previos de FIV o factores genéticos.

Etapa clave del proceso FIV. Se seleccionan los mejores embriones y se colocan cuidadosamente en el útero mediante un procedimiento rápido, indoloro y sin necesidad de anestesia.

Procedimiento que permite identificar el sexo del embrión antes de la transferencia, ya sea por decisión médica o familiar. Se realiza mediante métodos genéticos de alta precisión y bajo control ético estricto.

Permite analizar los embriones antes de su implantación para detectar posibles alteraciones genéticas. Recomendado para parejas con antecedentes hereditarios o abortos recurrentes.

Procedimientos quirúrgicos que permiten obtener espermatozoides directamente de los tejidos testiculares o epididimarios cuando no están presentes en el semen.
También incluye la maduración controlada de ovocitos para optimizar el éxito en FIV o ICSI.

Intervenciones mínimamente invasivas para corregir alteraciones uterinas, miomas o adherencias. Reducen el dolor, las cicatrices y los tiempos de recuperación, mejorando las condiciones de fertilidad.

Procedimiento ambulatorio y seguro para recuperar espermatozoides en casos de azoospermia. Se realiza bajo sedación y permite su uso posterior en tratamientos FIV o ICSI.

Preserva la posibilidad de tener hijos después de tratamientos como quimioterapia o radioterapia. Incluye congelación de óvulos, semen o tejido ovárico antes del procedimiento oncológico.

Protocolos especializados para hombres y mujeres con diabetes que buscan preservar su fertilidad y lograr embarazos planificados de manera segura y saludable.

Permite congelar embriones de alta calidad para su uso en ciclos posteriores sin repetir la estimulación ovárica.
Una opción segura, confiable y con excelentes resultados a largo plazo.





Conoce los distintos testimonios de nuestros pacientes. Ellos decidieron elegirnos, y sus vidas dieron un giro
Completa el siguiente formulario y uno de nuestros especialistas te compartirá los precios y tratamientos más adecuados según tu diagnóstico.
Te brindaremos una orientación clara, sin compromiso, para que tomes la mejor decisión.